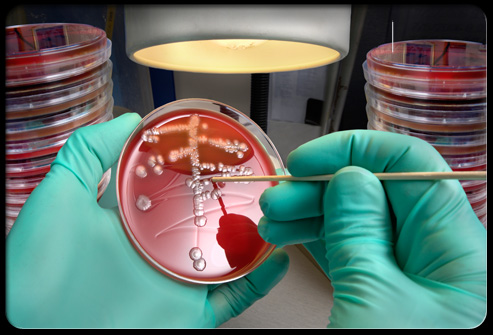
Cefixime rất hiệu quả trong điều trị c&aacute;c bệnh nhiễm tr&ugrave;ng do vi khuẩn g&acirc;y n&ecirc;n

Tìm Hiểu Tác Dụng Của Thuốc Cefixime 100mg
Có thể bạn quan tâm
Cefixime 100mg là một loại kháng sinh chuyên dùng trong điều trị một số loại bệnh nhiễm khuẩn. Cùng tìm hiểu kỹ hơn về loại thuốc này nhé.
Công dụng của thuốc Cefixime 100mg
Cefixime được sử dụng để điều trị nhiều loại bệnh nhiễm trùng do vi khuẩn. Thuốc này được biết đến như một loại kháng sinh cephalosporin, hoạt động bằng cách ngăn chặn sự phát triển của vi khuẩn.
Cefixime rất hiệu quả trong điều trị các bệnh nhiễm trùng do vi khuẩn gây nên
Cefixime 100mg chỉ điều trị nhiễm trùng do vi khuẩn. Nó sẽ không hoạt động đối với nhiễm virus (như cảm lạnh thông thường, cúm…). Sử dụng trong trường hợp không cần thiết hoặc lạm dụng bất kỳ loại kháng sinh nào có thể dẫn đến giảm hiệu quả của nó. Thuốc có tác dụng tốt trên vi khuẩn gram âm, bền vững với betalactamse và đạt được nồng độ diệt khuẩn trong dịch não tuỷ. Tuy nhiêm trên vi khuẩn gram dương thì tác dụng kém penicillin và cephalosporin thế hệ I.
Hiệu lực lâm sàng đã được chứng minh trên nhiều bệnh nhiễm khuẩn gây ra bởi những chủng gây bệnh phổ biến như: Streptococcus pyogennes; S. agalactiae, S.pneumoniae; E.coli; Proteus mirabilis; Klebsiella species; Haemophilus influenzae, H.Prarainfluenzae (kể cả những chủng tiết ra &beta-lactamase) Moraxella catarrhalis (kể cả những chủng tiết ra &beta-lactamase); Neisseria menigitidis; N.gonorrhoeae (kể cả những chủng tiết ra penicillinase)…
Cách sử dụng thuốc Cefixime 100mg
Cefixime 100mg được bào chế dạng thuốc bột và đóng hộp 12 gói x 2g.
Liều dùng thuốc thường là một lần một ngày, hoặc hai lần một ngày ở trẻ em (cứ sau 12 giờ). Liều lượng thuốc được dựa trên tình trạng sức khỏe của bạn và sự đáp ứng với điều trị. Với trẻ em, liều cũng dựa trên trọng lượng.
– Dạng viên 100mg: sử dụng cho người lớn và trẻ em cân nặng ≥ 30kg, liều thường dùng hàng ngày được khuyến cáo là uống 100mg cefixime, 2lần/ngày. Có thể điều chỉnh liều tùy theo tuổi tác, thể trọng và triệu chứng bệnh.
Trường hợp nhiễm khuẩn trầm trọng và dai dẳng, có thể tăng liều lên đến 200mg, 2lần/ngày.
Để có hiệu quả tốt nhất, hãy dùng Cefixime trong khoảng thời gian cách đều nhau. Duy trì sử dụng thuốc này cho đến khi đủ liều lượng quy định, ngay cả khi các triệu chứng biến mất sau một vài ngày. Ngừng thuốc quá sớm có thể cho phép vi khuẩn tiếp tục phát triển, điều này có thể dẫn đến tái phát nhiễm trùng.
Tác dụng phụ thuốc Cefixime 100mg
Đa phần những người sử dụng thuốc này không có tác dụng phụ nghiêm trọng. Các triệu chứng như đau dạ dày, tiêu chảy, buồn nôn, đầy hơi, đau đầu hoặc chóng mặt có thể xảy ra trong quá trình dùng thuốc. Nếu bất kỳ tác dụng nào trong số này xảy ra trong thời gian dài hoặc xấu đi, hãy thông báo cho bác sĩ kịp thời.
Hãy cho bác sĩ của bạn biết ngay lập tức nếu có bất kỳ tác dụng phụ hiếm gặp nhưng rất nghiêm trọng này xảy ra: đau bụng, đau bụng dữ dội, buồn nôn, nôn kéo dài, vàng mắt hoặc da, nước tiểu sẫm màu, mệt mỏi bất thường, dấu hiệu nhiễm trùng mới (ví dụ, đau họng kéo dài, sốt), dễ bầm tím, chảy máu, dấu hiệu của các vấn đề về thận (như thay đổi lượng nước tiểu), thay đổi về tinh thần, tâm trạng (như nhầm lẫn).
Sử dụng Cefixime 100mg trong thời gian dài hoặc lặp đi lặp lại có thể dẫn đến bệnh tưa miệng hoặc nhiễm trùng nấm âm đạo (nhiễm nấm miệng hoặc âm đạo). Liên hệ với bác sĩ của bạn nếu bạn nhận thấy các mảng trắng trong miệng, thay đổi dịch tiết âm đạo hoặc các triệu chứng lạ khác.
Tương tác thuốc
Tương tác thuốc có thể thay đổi cách thuốc của bạn hoạt động hoặc tăng nguy cơ tác dụng phụ nghiêm trọng. Liệt kê danh sách tất cả các loại thuốc bạn đang sử dụng (bao gồm cả thuốc kê toa, thuốc không kê toa và các sản phẩm thảo dược) và chia sẻ với bác sĩ của bạn. Không bắt đầu dùng, dừng hoặc thay đổi liều lượng của bất kỳ loại thuốc nào mà không có sự chấp thuận của bác sĩ.

Cần tuyệt đối thận trọng khi sử dụng Cefixime 100mg
Cefixime 100mg có thể gây ra kết quả dương tính giả với một số sản phẩm xét nghiệm nước tiểu trong bệnh tiểu đường (loại cupric sulfate). Thuốc này cũng có thể ảnh hưởng đến kết quả của một số xét nghiệm trong phòng thí nghiệm. Hãy chắc chắn rằng nhân viên phòng thí nghiệm và tất cả các bác sĩ của bạn biết bạn sử dụng thuốc này.
Lưu ý
Trước khi dùng Cefixime, hãy nói với bác sĩ nếu bạn bị dị ứng với nó; hoặc với penicillin hoặc kháng sinh cephalosporin khác (ví dụ: cephalexin); hoặc nếu bạn có bất kỳ phản ứng dị ứng nào khác. Các thành phần trong Cefixime có thể gây ra phản ứng dị ứng hoặc các vấn đề khác.
Cho bác sĩ biết tiền sử bệnh của bạn, đặc biệt với bệnh thận và bệnh đường ruột (như viêm đại tràng).
Cefixime có thể khiến vắc-xin vi khuẩn sống (như vắc-xin thương hàn) không hoạt động tốt. Không được tiêm chủng trong khi sử dụng thuốc này trừ khi bác sĩ khuyến cáo.
Với phụ nữ mang thai và cho con bú, cần tham khảo kỹ ý kiến của các bác sĩ trước khi sử dụng.
Trên đây là một số chia sẻ về thuốc kháng sinh Cefixime 100mg. Chú ý, đây chỉ là những thông tin mang tính tham khảo, các bạn không nên tự ý dùng thuốc Cefixime khi chưa có khuyến cáo của các bác sĩ hoặc chuyên gia y tế.
Cao đẳng Dược TPHCM tổng hợp
Từ khóa » Công Dụng Của Thuốc Cefixime 100mg
-
Cefixime Là Thuốc Gì? Công Dụng & Liều Dùng Hello Bacsi
-
Thuốc Cefixim: Công Dụng, Liều Dùng Và Tác Dụng Phụ | Vinmec
-
Thuốc Kháng Sinh Cefixim 100Mg điều Trị Nhiễm Trùng (Hộp 10 Gói)
-
Cefixim 100mg Là Thuốc Gì? Công Dụng Và Cách Dùng
-
Thuốc Kháng Sinh Cefixim 100mg Hộp 10 Gói-Nhà Thuốc An Khang
-
Công Dụng, Liều Dùng Và Tác Dụng Phụ Của Thuốc Cefixim - AiHealth
-
Cefixime 100mg - Thuốc Biệt Dược, Công Dụng , Cách Dùng
-
Cefixim 100mg - Thuốc Biệt Dược, Công Dụng , Cách Dùng
-
Thuốc Cefixim 100 Mg: Liều Dùng & Lưu ý, Hướng Dẫn Sử Dụng, Tác ...
-
Cefixime MKP 100 - Mekophar
-
Thuốc Cefixime MKP 100: Tác Dụng, Liều Dùng, Tương Tác Thuốc
-
Thuốc Cefixim 100mg: Công Dụng, Liều Dùng, Lưu ý Tác Dụng Phụ ...
-
Cefixime 100mg MD Pharco - Thuốc điều Trị Nhiễm Khuẩn
-
[ Thuốc Cefixim ] : Công Dụng + Liều Dùng + Hướng Dẫn Sử Dụng !